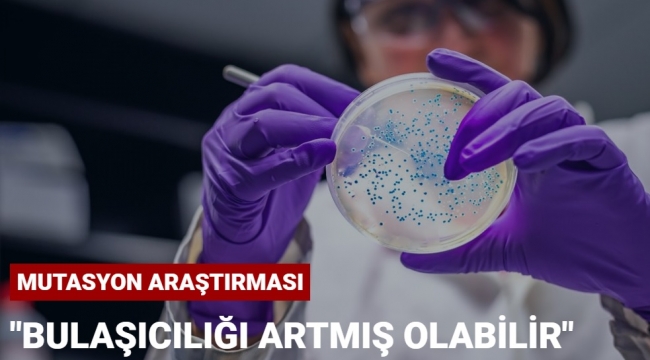

Florida'daki Scripps Araştırma Enstitüsü" araştırmacıları corona virüsün mutasyona uğradığını ancak bunun küresel salgının gidişatını değiştirecek düzeyde olup olmadığının yapılacak çalışmalar sonrasında belli olacağını açıkladı.
Uzmanlar, mutasyona uğrayan virüsün insan hücreleri arasında bulaşıcılığının artması nedeniyle, ABD ve Latin Amerika'da çok yüksek sayıda vaka görülmüş olabileceği ihtimali üzerinde duruyor.
DSÖ 'NORMAL' DEMİŞTİ
Dünya Sağlık Örgütü daha önce, corona virüste şimdiye kadar görülen mutasyonların normal olduğunu, bulaşıcılığı artırdığına ya da daha ölümcül bir hale getirdiğine yönelik ellerinde henüz bir veri olmadığını söylemişti.
Uzmanlar, mutasyona uğrayan virüsün insan hücreleri arasında bulaşıcılığının artması nedeniyle, ABD ve Latin Amerika'da çok yüksek sayıda vaka görülmüş olabileceği ihtimali üzerinde duruyor.
DSÖ 'NORMAL' DEMİŞTİ
Dünya Sağlık Örgütü daha önce, corona virüste şimdiye kadar görülen mutasyonların normal olduğunu, bulaşıcılığı artırdığına ya da daha ölümcül bir hale getirdiğine yönelik ellerinde henüz bir veri olmadığını söylemişti.